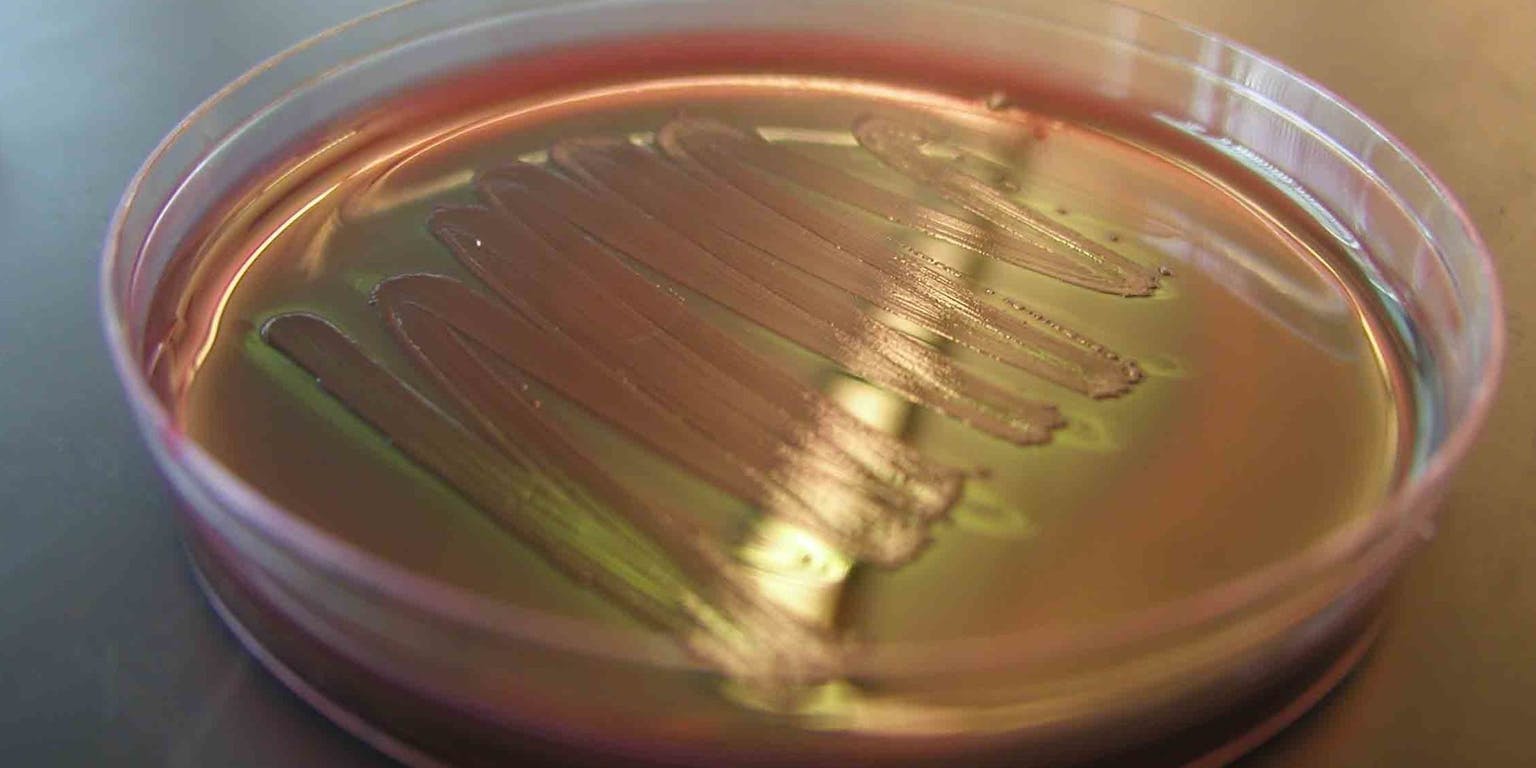

Onze darmflora staat steeds meer in de belangstelling. Iedereen heeft een bijzondere set darmbacteriën die invloed heeft op onze gezondheid, onze aanleg om dik te worden en zelfs om bepaalde ziektes als kanker te ontwikkelen. Maar wat als wetenschappers een bacterie ontwerpen met eigenschappen die onze darmflora beïnvloedt? Met synthetische biologie is dit mogelijk. Zou jij zo’n synthetische bacterie in je lichaam toelaten?
In de dikke darm leven veel darmbacteriën, deze noemen we de darmflora. Bij een gezonde darmflora zijn de nuttige en schadelijke bacteriën in evenwicht met elkaar. Maar wat als we synthetische bacteriën toevoegen aan het lichaam? Heeft dit invloed op onze darmbacteriën?

Yakult: bomvol bacteriën. Maar of je er nou echt slanker van wordt…
Wikimedia Commons, Dezzawong, CC BY-SA 3.0Yakult
We krijgen voortdurend lichaamsvreemde bacteriën binnen, bijvoorbeeld bij de inname van voedsel. Soms voegen we dan bewust extra bacteriën toe aan ons lichaam. Denk maar eens aan het drankje Yakult, dat 6,5 miljoen bacteriën bevat.
Ook het ‘doneren’ van darmbacteriën staat in de belangstelling. Personen met ernstige darmproblemen zouden geholpen kunnen worden met darmbacteriën van een gezond persoon.
Afvallen met behulp van andermans darmbacteriën behoort daarbij eveneens tot de mogelijkheden: het is wetenschappers gelukt om poep met een bacteriesamenstelling van een slanke muis te transplanteren naar een muis met overgewicht. Muizen zonder darmflora, die bacteriën van dikke muizen kregen, werden dikker terwijl de andere muizen op gewicht bleven. Als deze methode ook succesvol blijkt bij mensen, kunnen personen met overgewicht sneller afvallen.
Deze voorbeelden gaan echter allemaal over het overzetten van in de natuur voorkomende bacteriën. Maar wat als je ze zelf kunt ontwerpen naar jouw voorkeur? Studenten van de IGEM-competitie (een internationale competitie op het gebied van synthetische biologie) slaagden er in 2009 in om de _E.coli_-bacterie zo aan te passen dat deze verschillende kleuren kon afgeven.
Met genen van verschillende organismen die codeerden voor een bepaalde kleur maakten de studenten een stuk DNA dat ze in de E.Coli bacterie plaatsten. Deze geprogrammeerde bacterie kan dienen als waarschuwingssysteem in water. Zodra de bacterie in aanraking komt met een giftige stof verandert hij van kleur.

Hoe zouden gekleurde E.Coli bacteriën eruit zien?
FlickrSynthetische bacteriën in het lichaam
Een ander IGEM-team richtte zich op de geur van de _E.Coli_-bacterie, die nogal stinkt. In 2006 lukte het de studenten om de nare geur van de bacterie zo aan te passen dat deze naar banaan rook. Ze verwijderden het gen dat de stinkende geur veroorzaakte in de bacterie en vervingen deze door een zelfgemaakt stuk DNA dat codeerde voor de aanmaak van bananenolie, een aangename geur.
“De toepassing van synthetische bacteriën op het lichaam is echter nog ver weg”, zegt Jan-Willem Veening, microbioloog aan de Rijksuniversiteit Groningen. “Wetenschappers zijn op dit moment voornamelijk bezig met het identificeren van de bacteriesamenstelling in een gezond mens. Deze samenstelling is zo complex, dat het op dit moment onvoorspelbaar is hoe de darmbacteriën reageren als je een synthetische bacterie toedient aan het lichaam.”

De pneumokokken-bacterie kan zich ontwikkelen tot een ziekteverwekker.
Wikimedia commonsVeenings team doet op dit moment onderzoek naar pneumokokken. Deze bacteriën komen bij alle mensen in de neusholte voor, zonder ziekteverschijnselen te geven. Soms veranderen deze onschuldige bacteriën echter in nare ziekteverwekkers die longontstekingen kunnen veroorzaken.
Veening en zijn team gebruiken de ontwerptechnieken van synthetische biologie om te achterhalen waarom sommige pneumokokken veranderen in ziekteverwekkers. “Mijn grote doel is om uiteindelijk een synthetische bacteriesamenstelling te maken die gebruikt kan worden om baby’s te beschermen. Baby’s zouden via de neus deze synthetische bacteriën toegediend krijgen waardoor ze beschermd raken tegen een longontsteking.”
Anti-kanker bacteriën
“Ik zie veel potentie voor synthetische biologie in de toekomst. Op dit moment vindt er bijvoorbeeld onderzoek plaats naar het gebruik van bacteriën als anti-kanker middel. Synthetische biologie zou in de toekomst kunnen bijdragen aan de detectie van afwijkingen door lichaamsvreemde bacteriën”, zegt Veening. Dit gaat op dezelfde manier als het opsporen van giftige stoffen in het water.
“De synthetische bacterie werkt in het lichaam als een biosensor. Hij wordt zo gemaakt dat hij bijvoorbeeld een kankercel kan identificeren en uitschakelen. Dit zijn natuurlijk geweldige toepassingen van synthetische biologie, maar dit soort onderzoek staat nog in de kinderschoenen”, zegt Veening.
Het merendeel van ons zal wellicht toestemmen om zo’n synthetische bacterie toe te laten in het lichaam als het ziektes als kanker op kan sporen. Maar zou je dit ook doen als er een pil bestond met een bacterie die je lekkerder laat ruiken?